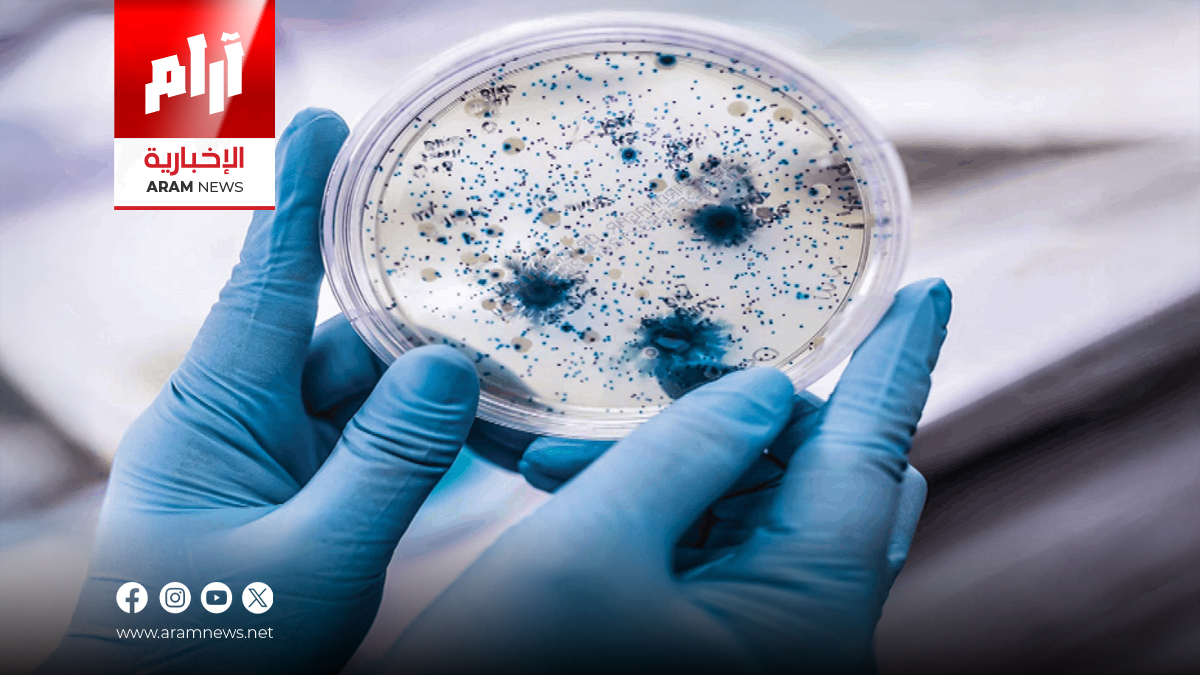
دراسة تكشف طبيعة الميكروبات في هواء المستشفيات والطائرات

دراسة تكشف طبيعة الميكروبات في هواء المستشفيات والطائرات
دراسة تكشف عالم الميكروبات في هواء المستشفيات والطائرات
أجرى فريق بحثي من جامعة نورث وسترن دراسة وُصفت بأنها الأولى من نوعها، بهدف فحص مستوى تلوث الهواء في البيئات المزدحمة مثل الطائرات والمستشفيات، وفهم طبيعة الميكروبات الموجودة في الهواء الذي نتنفسه يوميًا.
ميكروبات غير ضارة تهيمن على الهواء الداخلي
وأظهرت النتائج أن الهواء في الأماكن العامة كالمستشفيات والطائرات يحتوي غالبًا على ميكروبات غير ضارة ترتبط في الأساس بجلد الإنسان، وهو ما قد يخفّف من مخاوف أولئك الذين يعانون من رهاب الجراثيم.
أقنعة وجه وفلتر طائرات… أدوات لجمع العينات
اعتمد الباحثون على أدوات غير تقليدية مثل أقنعة الوجه وفلتر هواء الطائرات. ارتدى المتطوعون الأقنعة خلال رحلات داخلية ودولية، ثم أُرسلت بعد الهبوط في أكياس معقمة إلى المختبر، مع استخدام أقنعة غير مستخدمة للمقارنة. كما جُمعت عينات من أقنعة ارتداها موظفو المستشفيات أثناء العمل.
تنوع ميكروبي واسع… ومعظمها آمن
جمع الفريق الحمض النووي من الأقنعة، وكشف تحليل العينات عن وجود 407 أنواع ميكروبية مختلفة، معظمها بكتيريا شائعة مرتبطة بالجلد والهواء الداخلي. وظهرت بعض الميكروبات الممرِضة المحتملة، لكنها كانت نادرة جدًا ودون مؤشرات على عدوى نشطة.
مصدر الميكروبات الأساسي هو البشر
أظهرت الدراسة أن البشر أنفسهم—not البيئة—هم المصدر الأكبر للميكروبات المحمولة جواً، بما في ذلك أنواع بكتيرية موجودة على الجلد وفي الأماكن الداخلية المغلقة.
وجود جينات مقاومة المضادات لا يعني خطورة
ورغم رصد بعض جينات مقاومة المضادات الحيوية، أكد الباحثون أنها ليست دليلًا على وجود ميكروبات خطيرة، بل تعكس انتشار هذه الجينات في الهواء الداخلي.
توضيح من قائدة الدراسة: الهواء ليس الطريق الأهم لانتقال العدوى
أكدت قائدة الدراسة، الأستاذة المشاركة في الهندسة المدنية والبيئية إيريكا هارتمان، أن استخدام أقنعة الوجه أتاح جمع عينات دقيقة ومنخفضة التكلفة، موضحة أن انتقال العدوى لا يعتمد فقط على الهواء، وأن طرقًا أخرى—مثل التلامس المباشر والأسطح—تلعب دورًا أكبر في انتقال الأمراض.





